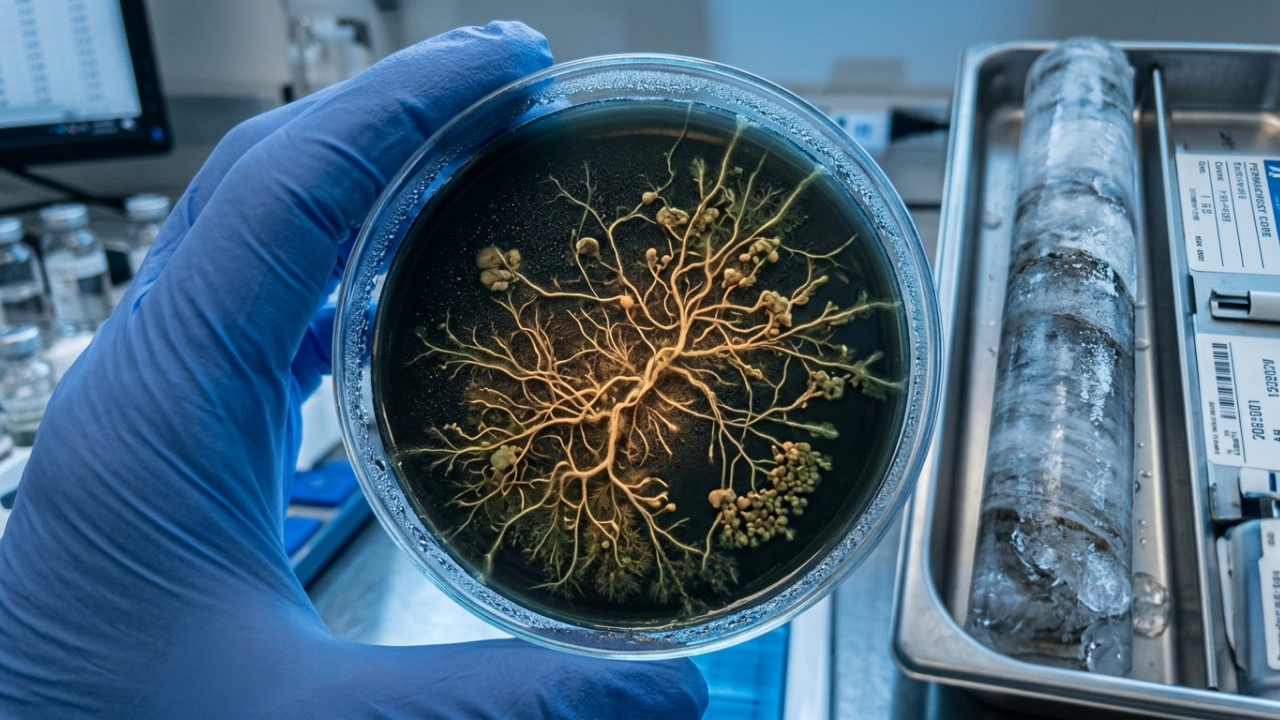
Micro-organismos congelados há 40 mil anos no permafrost do Alasca voltam à vida em laboratório e começam a devorar carbono ativamente

A imensidão gelada do Alasca guardava um segredo microscópico capaz de mudar nossa compreensão sobre o tempo e o clima. Imagine seres vivos que “dormiram” por 40 mil anos e, ao serem despertados hoje, mostram uma fome voraz por matéria orgânica.
Como micro-organismos congelados voltaram à vida?
Cientistas extraíram amostras de solo profundamente congelado, conhecido como permafrost, e as levaram para ambientes controlados em laboratório. Ao fornecer calor e nutrientes adequados, os pesquisadores observaram que micróbios ancestrais reativaram suas funções biológicas quase instantaneamente após milênios de dormência.
Um estudo publicado na revista Nature Communications revela que esses seres possuem uma resiliência incrível ao gelo, mantendo um estado de animação suspensa que permitiu o retorno imediato de seus metabolismos assim que o gelo derreteu.
Qual é o papel desses micróbios no consumo de carbono?
O canal Versada by Vane Costa, com 10,6 mil inscritos, abordou esse tema com profundidade. Uma vez despertos, esses micro-organismos passaram a devorar o carbono estocado no solo, transformando matéria orgânica antiga em energia e liberando gases no ambiente de forma acelerada.
As observações laboratoriais revelaram comportamentos preocupantes. Veja o que foi identificado:
- Os micróbios decompõem o carbono orgânico com eficiência superior à de espécies modernas em solos frios.
- A atividade metabólica gera calor local, acelerando ainda mais o derretimento do solo ao redor.
O derretimento do permafrost pode acelerar o aquecimento global?
O permafrost funciona como um gigantesco freezer que armazena o dobro de carbono do que existe atualmente em toda a nossa atmosfera. Quando esses micro-organismos despertam devido ao aumento das temperaturas globais, eles liberam esse enorme estoque de carbono acumulado.
A preocupação dos especialistas é que esse processo crie um ciclo vicioso: o solo esquenta, mais micróbios acordam, mais gases são emitidos e a temperatura do planeta sobe ainda mais rápido.

Como esses micróbios se comparam aos organismos modernos?
Diferente das bactérias que encontramos hoje na superfície, esses seres evoluíram em um ambiente com pressões e composições químicas distintas. Eles possuem uma estrutura genética otimizada para condições extremas, tornando-os verdadeiras máquinas de processamento orgânico.
Confira as principais diferenças entre esses micróbios e os organismos modernos:

Esses micro-organismos também competem agressivamente por recursos, podendo dominar biomas locais com rapidez surpreendente.
Leia também: Uma estrela que deveria ter morrido há bilhões de anos ainda está viva e cruzando nossa galáxia em velocidade absurda
Quais são os riscos de vírus milenares serem liberados?
O renascimento dessas bactérias levanta um alerta sobre outros “vizinhos” escondidos no gelo, como vírus antigos. Se micro-organismos congelados há milênios voltaram à vida com tanta vitalidade, o risco de patógenos desconhecidos ressurgirem é real e preocupante.
Embora o foco atual seja o impacto climático, a comunidade científica monitora possíveis riscos biológicos. O estudo dessas amostras é fundamental para preparar defesas contra ameaças que a humanidade não enfrenta há dezenas de milênios.
O post Micro-organismos congelados há 40 mil anos no permafrost do Alasca voltam à vida em laboratório e começam a devorar carbono ativamente apareceu primeiro em BM&C NEWS.



